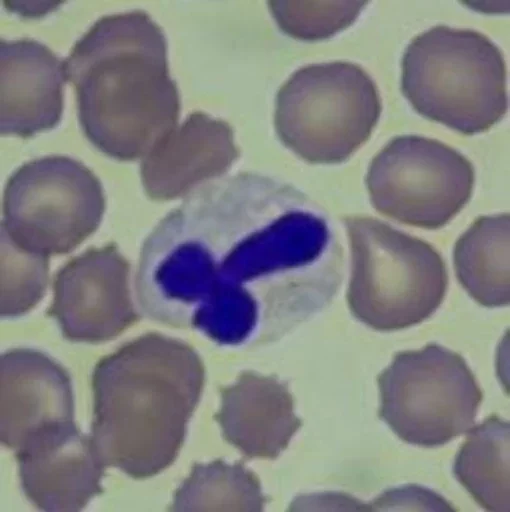
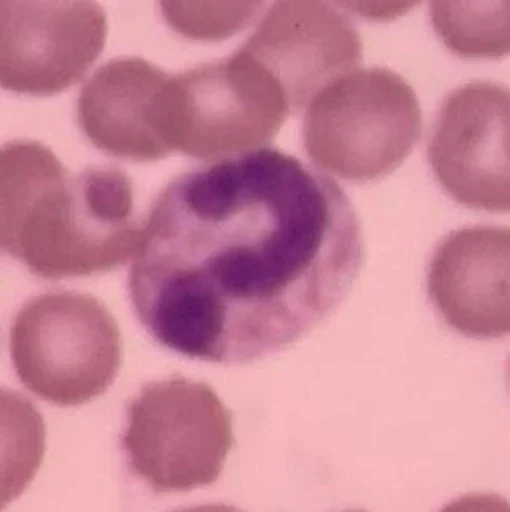

Статичные стикеры телеграм «Blood mood»
7 стикеров

💕

❤️
🖕

🐤

🫠
❓

😊
Набор статичных стикеров телеграм «Blood mood» (BloodMoodEosenophiles) состоит из 7 стикеров, добавлен в нашу базу 17 сентября 2025 06:40. Чтобы установить стикеры «Blood mood» в Telegram, нажмите кнопку «Добавить в Telegram», или воспользуйтесь постоянной ссылкой t.me/addstickers/BloodMoodEosenophiles.
❗ Если набор «Blood mood» нарушает правила или содержит запрещённый контент — сообщите нам.